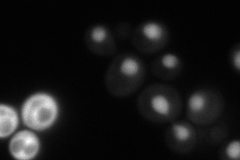
YJL125C
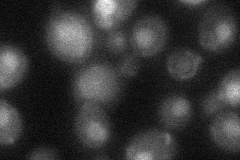
YJL125C

View description
Subunit of tRNA (1-methyladenosine) methyltransferase, with Gcd10p, required for the modification of the adenine at position 58 in tRNAs, especially tRNAi-Met; first identified as a negative regulator of GCN4 expression
Localization:
Intensity:
Fold change:
Significance:
-
C’ GFP library in SD

below threshold17.57 -
N' NOP1pr-GFP in SD
nucleus75.3385 -
N' TEF2pr-mCherry in SD

nucleus38.4504 -
N' NATIVEpr-GFP in SD

nucleus42.8972 -
N' TEF2pr-VC and Cyto-VN in SD
nucleus33.7605 -
C’ GFP library in SD+DTT

cytosol16.080.91No -
C’ GFP library in SD+H2O2

cytosol17.881.01No -
C’ GFP library in Starvation Media

cytosol28.951.64No -
C’ GFP library on the background of Pup2-DaMP

below threshold -
C’ GFP library on the background of CCT mutant

below threshold16.45760.935838No
